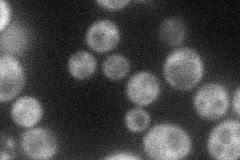
YCR093W
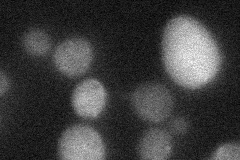
YCR093W
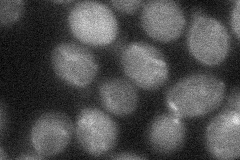
YCR093W

View description
Component of the CCR4-NOT complex, which has multiple roles in regulating mRNA levels including regulation of transcription and destabilizing mRNAs by deadenylation; basal transcription factor
Localization:
Intensity:
Fold change:
Significance:
-
C’ GFP library in SD

below threshold16.38 -
N' NOP1pr-GFP in SD
cytosol29.806 -
N' TEF2pr-mCherry in SD

cytosol16.9379 -
N' NATIVEpr-GFP in SD
punctate22.0228 -
N' TEF2pr-VC and Cyto-VN in SD
cytosol31.3497 -
C’ GFP library in SD+DTT

cytosol14.470.88No -
C’ GFP library in SD+H2O2

cytosol21.661.32No -
C’ GFP library in Starvation Media

cytosolN/AN/AYes -
C’ GFP library on the background of Pup2-DaMP

below threshold -
C’ GFP library on the background of CCT mutant

below threshold19.04351.16219No
